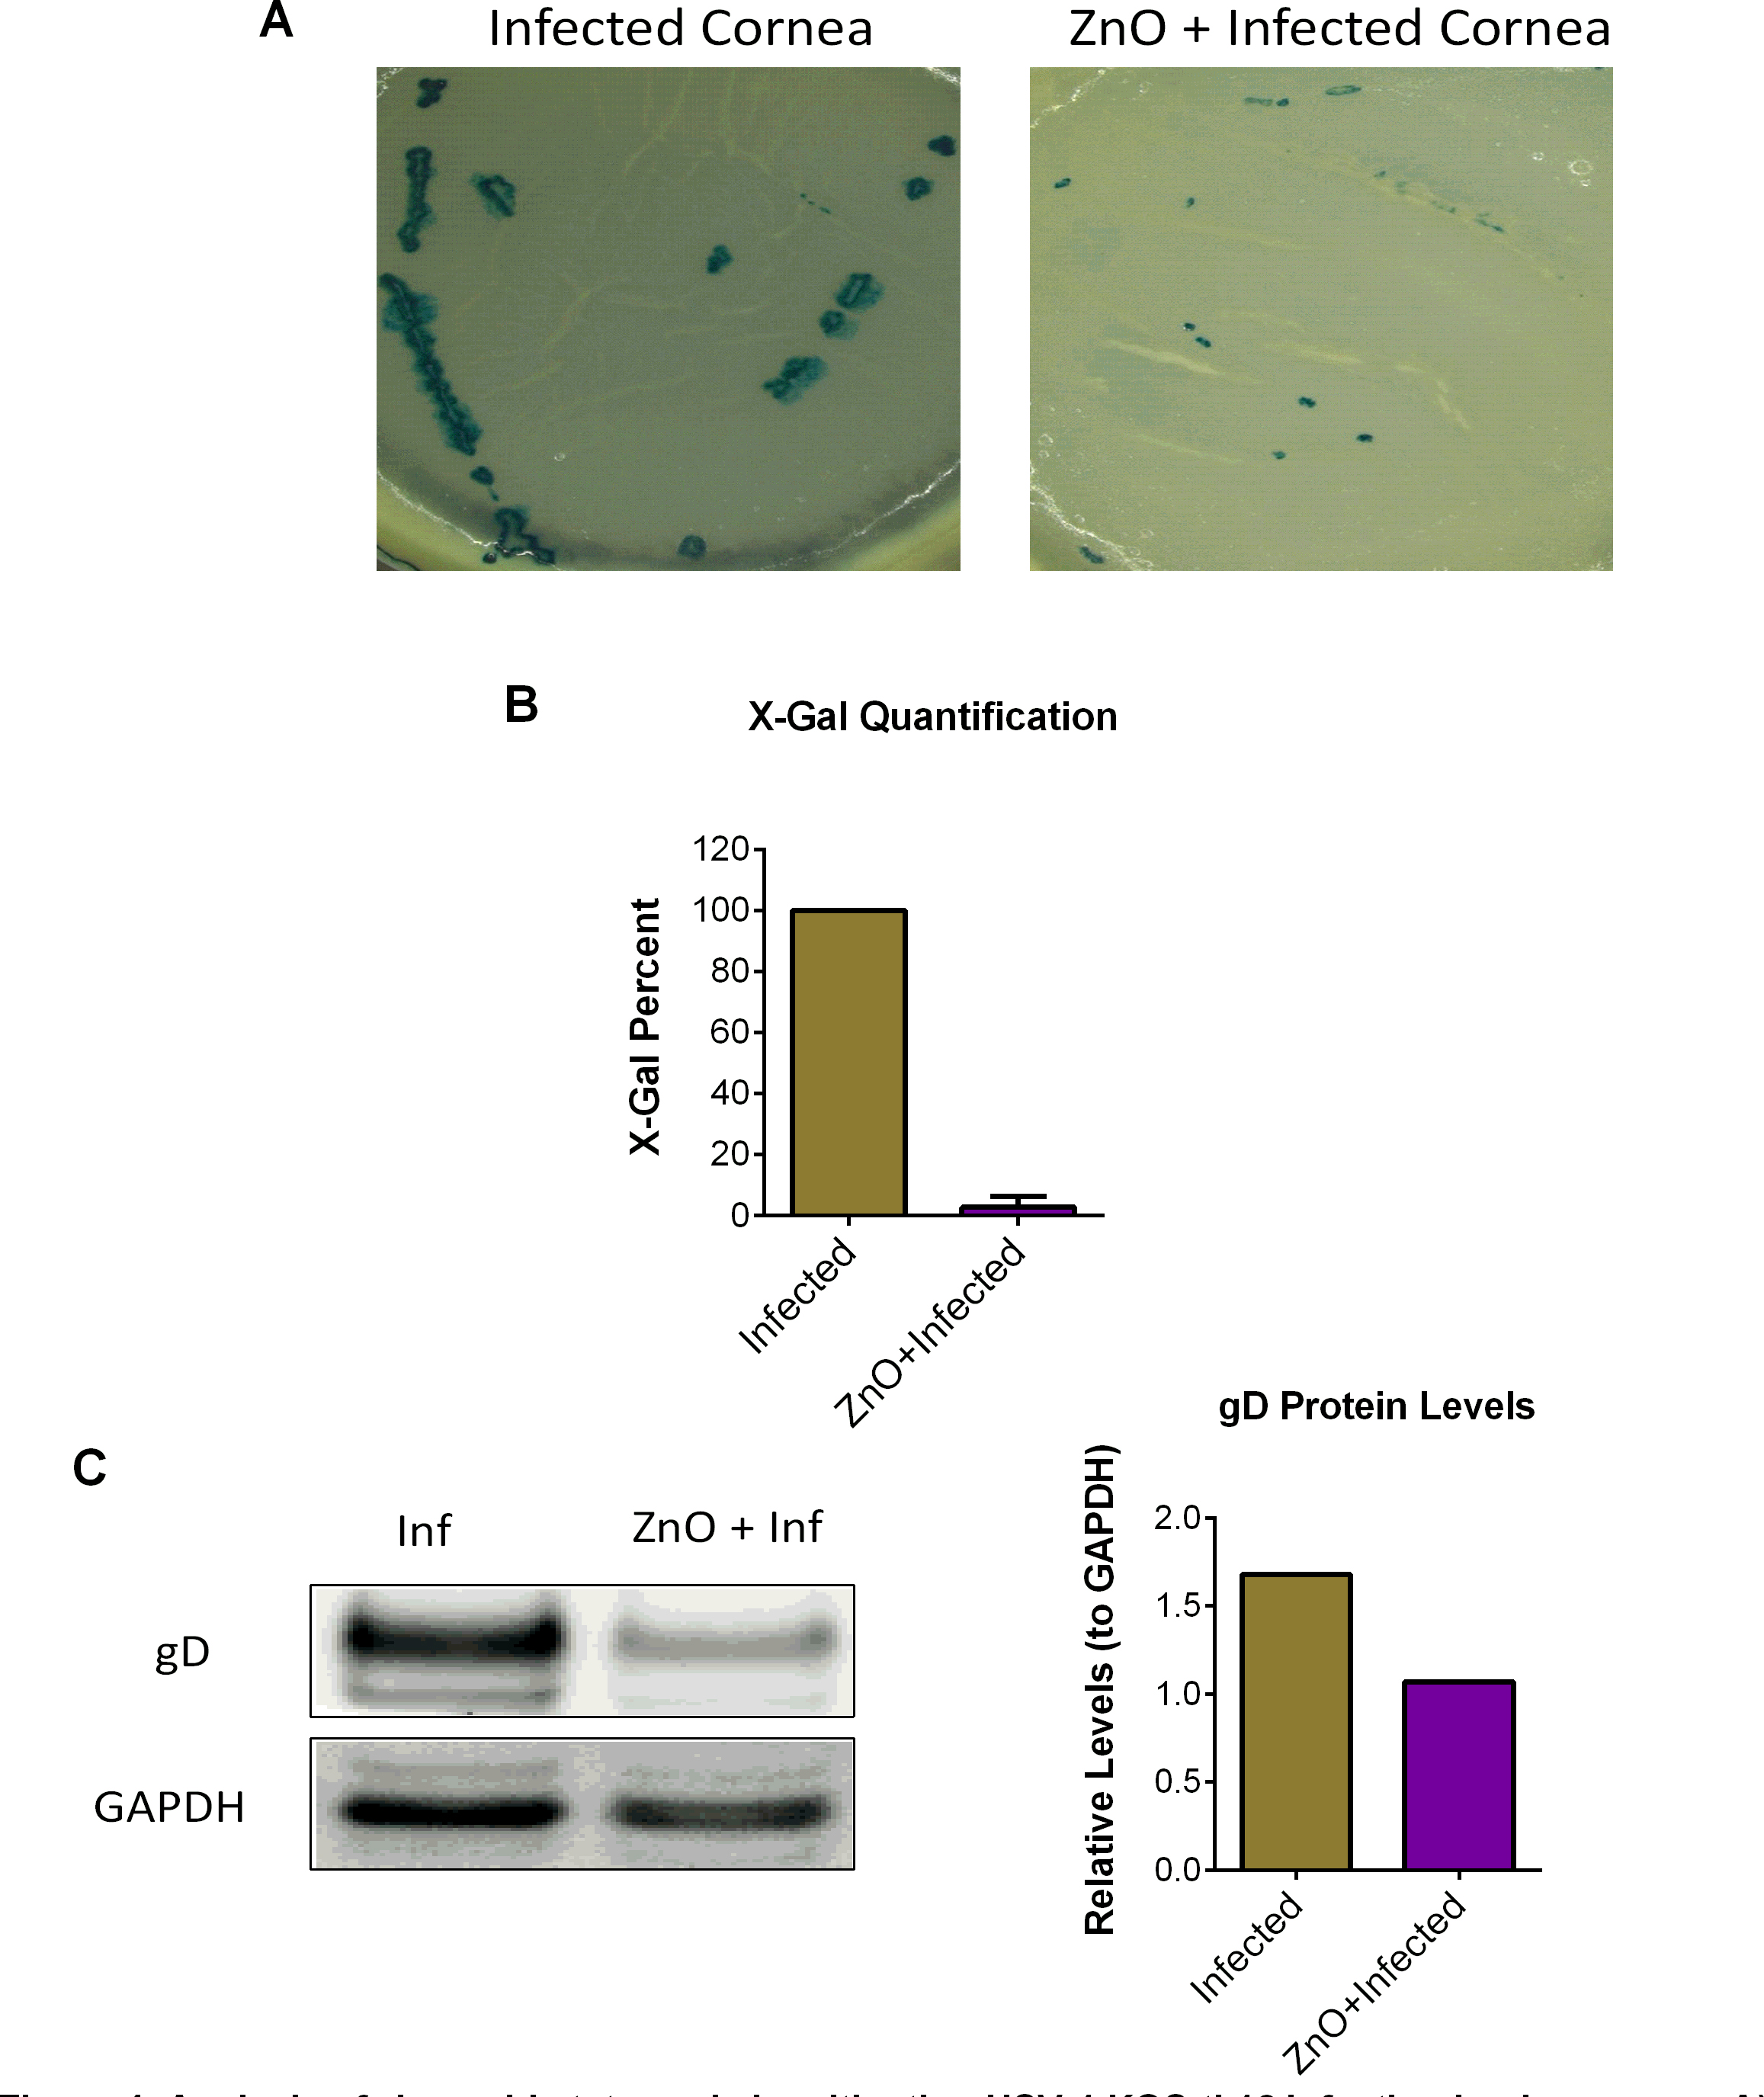

Figure 4. Analysis of zinc oxide tetrapods in mitigating HSV-1(KOS)tk12 infections in pig corneas. A: Representative modular stereo microscope imaging of infected and zinc oxide-treated infected pig corneas to assess viral
entry and spread via 5-bromo-4-chloro-3-indolyl-β-D-galactoside (X-gal) substrate. B: Quantification of viral entry and spread assessed by amount of blue present via Metamorph software. Significance was determined
by t-test: p<0.001. C: Representative immunoblot image (left panel) and quantification (right panel) of HSV-1 gD from untreated and zinc oxide-treated
infected pig corneal epithelial cell lysates.